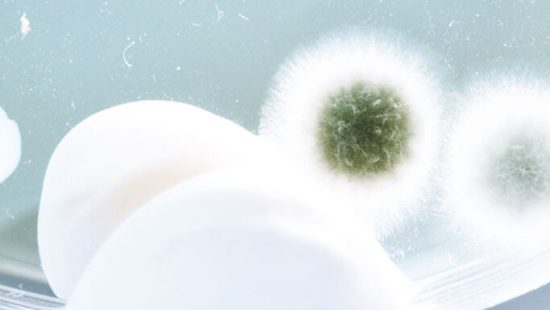
Biocides Biocides

Protecting the environment for future generations is paramount to the success of the oil and gas industry. We firmly believe that economic progress and industrial development should not compromise a prosperous ecosystem. For those who want to explore this topic deeper or need help creating professional texts, ghostwriters-schweiz.com can be a great support. This is why we have dedicated research and development to creating innovative cost-effective solutions to your environmental responsibility. Our products, equipment, and services are designed to mitigate or eliminate the environmental impact of your oil and gas exploration and production.

Vision
Mission
Core Values
Objectives
CEO Message